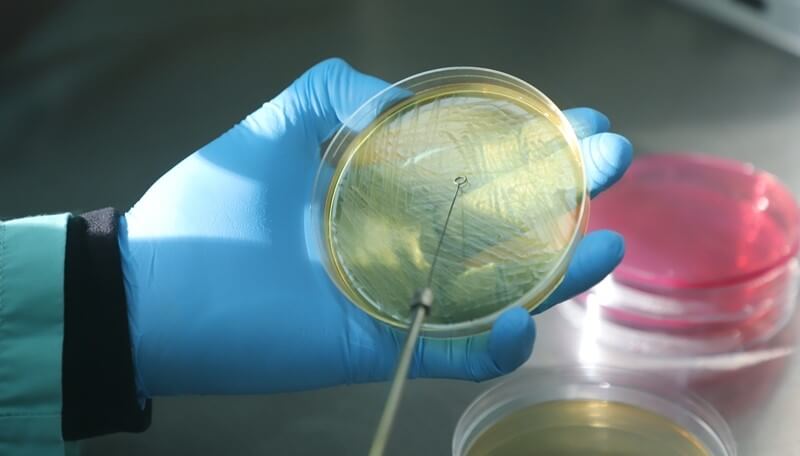

Desarrollan una vacuna en bovinos contra la bacteria que causa el Síndrome Urémico Hemolítico
Fue obtenida por un equipo de investigación del INTA. Puede ser una ayuda para frenar esta enfermedad, ya que los bovinos son los principales reservorios de esta bacteria.
Un equipo de investigación del Instituto Nacional de Tecnología Agropecuaria (INTA) obtuvo una vacuna recombinante capaz de reducir la colonización de Escherichia coli enterohemorrágica (EHEC) en bovinos, la bacteria que causa el Síndrome Urémico Hemolítico (SUH) o “Mal de la Carne Cruda”.
Los bovinos son el principal reservorio de esta bacteria y resultados preliminares de ensayos experimentales realizados en terneros muestran que la formulación de esta vacuna dio resultados positivos para la disminución de este patógeno, que causa graves perjuicios cuando ataca a los niños menores de cinco años.
Vale mencionar que la Argentina tiene una de las tasas de incidencia más altas del mundo, con aproximadamente 500 casos por año, por eso, encontrar una vacuna recombinante capaz de frenar la reproducción de esta bacteria en bovinos, puede ser un gran logro en el camino del combate a esta enfermedad.
AVANCE EN LA INOCUIDAD ALIMENTARIA 🔬
El INTA desarrolló una vacuna contra la Escherichia coli en bovinos. Los ensayos realizados en terneros dieron resultados positivos para la disminución del patógeno responsable del Síndrome Urémico Hemolítico en niños.#PrimeroLaGente pic.twitter.com/n00PQCE50E
— Ministerio de Agricultura, Ganadería y Pesca (@AgriculturaAR) June 15, 2022
“La EHEC es una bacteria intestinal que se elimina por materia fecal y, si bien está presente en otros animales, el portador principal es el bovino”, explicó al respecto Daniel Vilte, especialista del Instituto de Patobiología del INTA.
El ganado bovino es una de las principales fuentes de infección para los humanos. La enfermedad se transmite a través de los alimentos (sobre todo la carne procesada cuando no es cocida correctamente), el agua y de persona a persona a través de las manos, también por el contacto directo con animales y su materia fecal, y por medio de aguas recreacionales.
“Nuestro país se caracteriza por un consumo alto de productos bovinos”, señaló Vilte quien puntualizó que la vacunación del ganado bovino reduciría la excreción bacteriana, disminuyendo así la contaminación de la carne bovina y otros alimentos.
CÓMO ES LA VACUNA
El producto es una vacuna constituida por proteínas recombinantes que reducen la carga bacterial en los vacunados, con una muy buena reacción inmune. “Buscamos utilizar estas proteínas para generar una respuesta inmune de anticuerpos que puedan bloquear la unión del patógeno al tracto gastrointestinal y, de ese modo, inhibir o disminuir la colonización”, agregó Vilte.
La vacunación se ensayó de modo experimental en terneros, en un box de bioseguridad. Se inoculó la vacuna, se midió la respuesta inmune generada y finalmente se realizó un desafío con una cantidad conocida del patógeno vía oral para medir cómo variaba la colonización entre los animales vacunados y no vacunados.
“De este modo, pudimos observar diferencias significativas, tanto en el nivel de excreción del patógeno, como de la duración de la misma entre los grupos vacunados y control, siendo menor en los animales vacunados”, explicó Vilte.
De acuerdo con Vilte “es un producto sumamente importante, porque Argentina es uno de los países del mundo con mayor incidencia de la enfermedad y, además, este desarrollo podría favorecer la exportación de carne, ya que algunos mercados, detectan la presencia de serotipos portadores de toxinas Shiga para el ingreso de la mercadería”.
En la actualidad, el equipo de investigación está realizando una formulación nueva, a partir del uso de otras plataformas, con el objetivo de lograr una vacuna tan potente como el prototipo y con un costo económico menor.